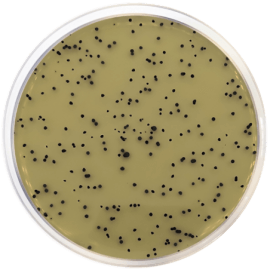
main product photo

Close
TSC AGAR BASE (ISO 7937) 500 grams/bottle
SKU
CDL/1029
Brand
CONDALAB
Pre-order (Deliver in 8 to 12 weeks)
T.S.C. Agar Base (Tryptose Sulfite Cycloserine) was originally formulated by Harmon for presumptive identification and enumeration of Clostridium perfringens from food. This medium has been documented as one of the most useful media for the quantitative recovery of C. perfringens, while suppressing growth of other facultative anaerobes. This media is recommended by ISO Normative Committee. Depending on the formula, supplements are added to increase the selectivity of the medium. Egg Yolk Emulsion (Cat. 5152) supplement is added for the demonstration of lecithinase activity, and after incubation, lecithinase-producers produce an opaque area in the colony surroundings.
The superior nutrient base provides optimal conditions for the development of Clostridia. Tryptose and soy peptone provide nitrogen, vitamins, minerals and amino acids essential for growth. Yeast extract is source of vitamins, particularly the B-group, essential for bacterial growth. Ferric ammonium citrate and disodium disulfite are H2S indicators. Bacteriological agar is the solidifying agent. Cycloserine inhibits the accompanying bacterial flora and may cause the colonies which develop to remain smaller.
Colonies producing hydrogen sulfide are characterized by a blackening due to the reaction with the ferric salt. The degradation of the egg yolk lecithin produces insoluble products which accumulate around the colonies, forming a white precipitate. After 24 hours incubation, all black colonies, lecithinase positive as well as the lecithinase negative ones, have to be considered as positive presumptive C. perfringens and the corresponding confirmation tests have to be made.
T.S.C. Agar Base (Tryptose Sulfite Cycloserine) was originally formulated by Harmon for presumptive identification and enumeration of Clostridium perfringens from food. This medium has been documented as one of the most useful media for the quantitative recovery of C. perfringens, while suppressing growth of other facultative anaerobes. This media is recommended by ISO Normative Committee. Depending on the formula, supplements are added to increase the selectivity of the medium. Egg Yolk Emulsion (Cat. 5152) supplement is added for the demonstration of lecithinase activity, and after incubation, lecithinase-producers produce an opaque area in the colony surroundings.
The superior nutrient base provides optimal conditions for the development of Clostridia. Tryptose and soy peptone provide nitrogen, vitamins, minerals and amino acids essential for growth. Yeast extract is source of vitamins, particularly the B-group, essential for bacterial growth. Ferric ammonium citrate and disodium disulfite are H2S indicators. Bacteriological agar is the solidifying agent. Cycloserine inhibits the accompanying bacterial flora and may cause the colonies which develop to remain smaller.
Colonies producing hydrogen sulfide are characterized by a blackening due to the reaction with the ferric salt. The degradation of the egg yolk lecithin produces insoluble products which accumulate around the colonies, forming a white precipitate. After 24 hours incubation, all black colonies, lecithinase positive as well as the lecithinase negative ones, have to be considered as positive presumptive C. perfringens and the corresponding confirmation tests have to be made.
| Brand | CONDALAB |
|---|
Write Your Own Review

Validate your login